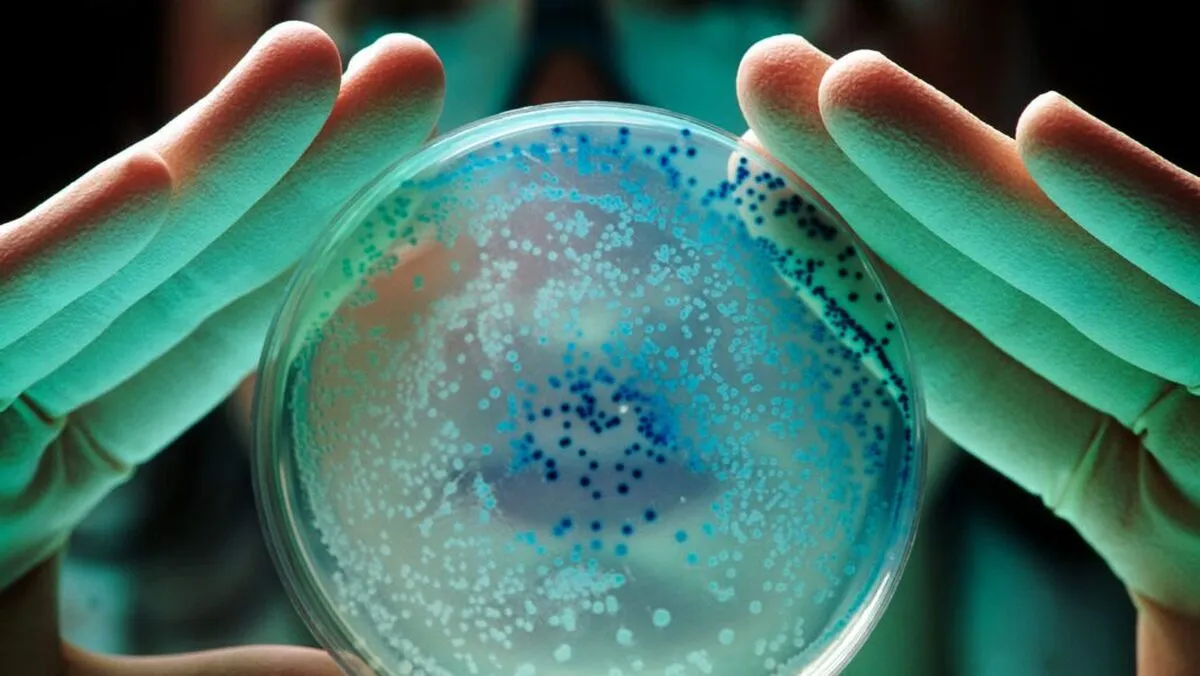

How Mysterious Last-Resort Antibiotics Kill Bacteria?!
New high-resolution microscope images show that a class of antibiotics called polymyxins crystallize the cell membranes of bacteria. The honeycomb-shaped crystals that form turn the microbes’ usually supple skins of fat molecules into thin brittle sheets. When the petrified membranes break, the bacteria die, the journal Nature Communications reported.
The finding was a total surprise, says Sebastian Hiller, a structural biologist at the University of Basel in Switzerland.
Hiller, biophysicist Selen Manioğlu and their colleagues had been using the antibiotics as a control for a different experiment. When the researchers turned on their microscopes, “we saw these waffles,” Hiller says. “I immediately recognized, wow, this must be something special.”
Polymyxin antibiotics like colistin were discovered in the 1940s and are now used as a powerful last-ditch defense against bacteria that have evolved resistance to most other drugs. Researchers already knew that polymyxins somehow interfere with bacterial cell membranes. But nobody had imagined a scenario like the “waffles” the team discovered.
In the new study, Hiller and colleagues exposed bits of cell membrane from Escherichia coli to varying concentrations of colistin. Imaging with atomic force microscopy revealed that crystals formed at the minimum concentrations required to kill the bacteria. Colistin-resistant strains exposed to the drug didn’t form crystals.
The results indicate that polymyxins work by arranging the cell membrane into a crystalline structure that leaves it brittle and vulnerable. “That’s something that has not even remotely been hypothesized so far,” says Markus Weingarth, a biochemist at Utrecht University in the Netherlands who was not involved in the work. “It’s a very important study. I’d even say it’s a breakthrough.”
How exactly polymyxins crystallize cell membranes remains unclear. That’s a problem because some bacteria have developed resistance to polymyxins and are becoming more widespread. Without more studies like this one to help reveal how the drugs work, scientists can’t effectively modify the antibiotics to make them more effective, Weingarth says.
4155/v





















